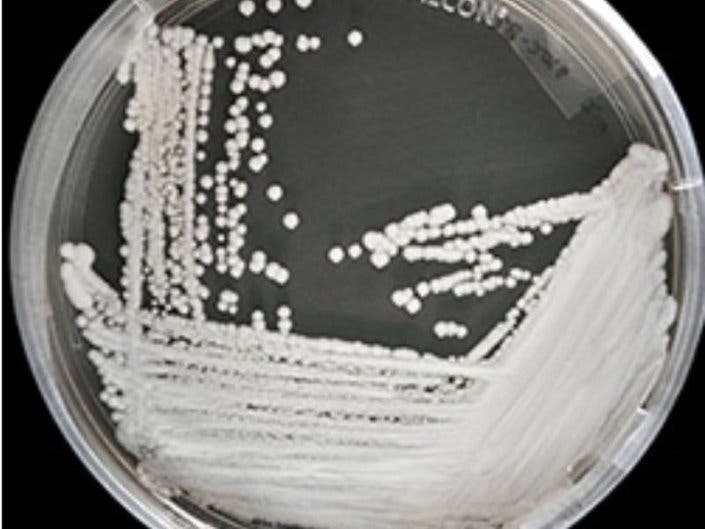

Health & Fitness
Deadly 'Superbug' Threat to New York Increases
The fungus is difficult to identify and is resistant to multiple antifungal drugs.
An increase in life-threatening illnesses resulting from a deadly fungal infection has been reported in the New York area. According to the Centers for Disease Control, the number and type of clinical Candida auris cases in New York State alone is 309, as of Feb. 28.
There are more than 100 in New Jersey, and the CDC said that, as of March 29, the case count in the entire United States is 617. In 2017, the CDC said New York had 92 confirmed cases and New Jersey had 27.
The infection is caused by the yeast Candida auris, which can enter the bloodstream. This yeast is difficult to identify and is resistant to multiple antifungal drugs commonly used to treat Candida infections, the CDC said.
Find out what's happening in New Rochellefor free with the latest updates from Patch.
Last year, a man at the Brooklyn branch of Mount Sinai Hospital, who was in for abdominal surgery, became infected with C. auris, the New York Times said.

While he died 90 days later, tests showed that the fungus was everywhere in his room, and the hospital had to use special cleaning equipment and even rip out some ceiling and floor times to get rid of it completely.
Find out what's happening in New Rochellefor free with the latest updates from Patch.
In 2009, C. auris was first described in a patient in Japan. There is documented transmission of C. auris to U.S. patients from healthcare facilities in India, Pakistan, South Africa and Venezuela.
The CDC awarded Rutgers University a $300,000 contract in 2017 to fight the infection's spread as part of the CDC's Antibiotic Resistance Solutions Initiative. The team, led by David Perlin, executive director and professor of the Public Health Research Institute at Rutgers New Jersey Medical School, was working to find a way to more accurately and rapidly detect C. auris in patients and hospital environments.
"As reports of C. auris continue to mount within U.S. healthcare facilities, it is worrisome that the problem may grow much worse," Perlin said. "The keys to containing the epidemic are infection control, the development of molecular tools to reliably and rapidly identify the pathogen and a better understanding of its genetic profile that facilitates transmission within hospital environments."
Fungal infections often cause serious disease among patients with compromised immune systems or other debilitating conditions resulting in high morbidity and mortality. Globally, nearly 1.4 million deaths a year are attributed to invasive fungal infections, which is on par with deadly diseases like tuberculosis.
The CDC said that C. auris can cause serious illness in hospitalized patients. Symptoms may not be noticeable, because patients with C. auris infection are often already sick in the hospital with another serious illness or condition.
The fungus can cause many different types of infection, such as in the bloodstream, a wound or the ear.
Because symptoms can vary greatly, a laboratory test is needed to determine whether a patient has a C. auris infection.
Additional reporting by Tom Davis/Patch National Staff.
Get more local news delivered straight to your inbox. Sign up for free Patch newsletters and alerts.